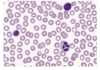
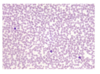
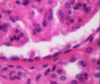

what is a cell?
cell is the smallest structural/functional unit of an organism consisting of many working components
homeostasis
process by which an internal environment is kept constant despite a constantly changing external environment
organelles
subcellular structure that has one or more specific functions within a cell
things to know about cells:
-not all cells are created equal
-different types and numbers of organelles (muscle cells contain high levels of mitochondria for energy)
-different organelles entirely (plant v animal cells)
cell division
mitosis
cells reproduce through this process im which the cell cleaves in two after key components have been duplicated
what do cells initially begin in?
interphase
cell grow and DNA is duplicated
cell division
four stages
prophase - metaphase - anaphase - telophase
prophase
-dna condenses into 23 distinct pairs of chromosomes
-nuclear membranes disperses
-each pair is joined together by a protein bridge called a centromere
metaphase
chromosomes align themselves midway between poles
anaphase
chromosome pairs separate and move toward opposite poles
telophase
-nuclear membrane begins to form and chromosomes decondense into chromatin
-cell membrane begins to pinch eventually cleaving in two (cytokinesis)
chromatin
a mixture of DNA and proteins that form the chromosomes found in the cells of humans and other higher organisms
cytokinesis
part of the cell division process during which the cytoplasm of a single eukaryotic cell divides into two daughter cells
tissues
4 types of tissues
- epithelial
- connective
- muscular
- nervous
epithelial tissue
shapes
- squamous
- cuboidal
- columnar
epithelial tissue
layers
- simple
- stratified
epithelial tissue
squamous function
forms a membrane that allows selective diffusion of materials
epithelial tissue
cuboidal function
-help with absorption, secretion, and excretion
-found in kidneys, pancreas, and salivary glands
epithelial tissue
columnar function
-primarily for protection / sometimes excretion, secretion, and excretion
-found in digestive, reproductive, and respiratory tracts, and more
epithelial tissue
ciliated columnar function
- aid with movement of substances
- found mostly in respiratory tract to help push mucous and air through
epithelial tissue
how many layers is simple?
one layer
epithelial tissue
how many layers is stratified?
numerous layers
epithelial tissue
difference between simple v stratified in terms of function
simple is very thin and good for filtration and absorbtion while stratified allows for more protection
epithelial tissue
how to name:
number of layers + shape + epithelial tissue